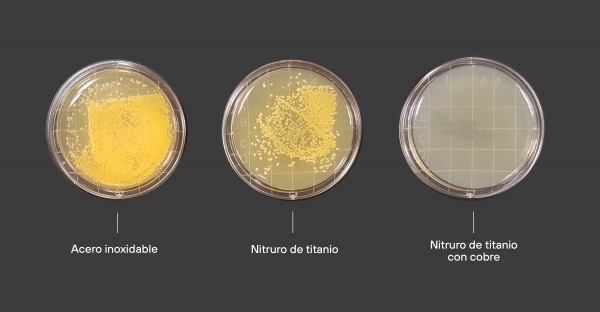

El presente artículo detalla la experiencia de Tekniker, miembro de Basque Research and Technology Alliance (BRTA), en superficies multifuncionales con potencial para ser aplicadas como superficies antivíricas, entendiendo así, que sean capaces de eliminar virus, hacer que su duración activa en la superficie sea más corta o conseguir superficies en las que no se adhieran o en las que se queden atrapados, impidiendo su transferencia por contacto. En cuanto a las posibles estrategias, Tekniker cuenta con experiencia demostrada en la fabricación y caracterización de superficies antibacterianas, higiénicas y biocidas, que pueden ser candidatas a investigar para su adaptación y aplicación en superficies antivirales.
Superficies que destruyen los patógenos mediante interacción física, química o emisión de agentes antibacterianos o biocidas
Tekniker ha desarrollado recubrimientos por deposición en vacío (en inglés, Physical Vapour Deposition –PVD-) de nitruros de titanio y de tántalo (TiN y TaN) con dopantes metálicos como el cobre para fabricar superficies que destruyen los patógenos. También recubrimientos basados en matrices de Sol-Gel y pinturas o lacas con nanopartículas metálicas y de óxidos embebidas que funcionan como agentes antibacterianos.
Estas tecnologías tienen la ventaja de que se pueden aplicar por esprayado por lo que tienen gran potencial de aplicación en muchos tipos de productos. También son tecnologías que se han aplicado para el microencapsulado de compuestos activos en forma líquida que luego se pueden dispersar en el interior de otros materiales. Además, también es posible realizar un micro/nanoestructurado de estos recubrimientos combinando así elementos antibacterianos activos y pasivos en una misma superficie. Por otra parte, mediante estas tecnologías de recubrimiento Tekniker ha desarrollado recubrimientos de óxidos de titanio (TiO2) fotocatalíticos capaces de eliminar compuestos orgánicos por la acción de los rayos ultravioleta (UV). Asimismo, usando tecnologías de electro oxidación por plasma (en inglés, Plasma Electrolitic Oxidation -PEO-), también se han desarrollado recubrimientos de óxidos de titano (TiO2) dopados con distintos iones sobre aleaciones de titanio para implantes antibacterianos.
Superficies que previenen el depósito de bacterias y la formación de biofilm- Superficies hidrofóbicas
Mediante tecnologías de láser pulsado a través del grabado directo de diferentes microestructuras sobre superficies metálicas, cerámicas, y polímeros (tanto en superficies planas con en superficies en 3D), Tekniker confiere propiedades de superhidrofobicidad para prevenir el depósito de bacterias y la posterior formación de biofilm.
El centro tecnológico cuenta, además, con experiencia sobre polímeros. En este sentido, el centro desarrolla piezas de inyección con propiedades hidrofóbicas a través de la microestructuración del molde. Por otra parte, es capaz de fabricar nano- micro- y estructuras jerárquicas (nano+micro) para conferir superhidrofobicidad a polímeros en film mediante tecnologías de nano impresión y de roll to roll.
Además de la capacidad de caracterizar las diferentes muestras fabricadas (ángulo de contacto, microscopía electrónica -SEM-, perfilometría, microscopía de fuerza atómica -AFM-), también estudia las propiedades antibacterianas de estas superficies para E. Coli y S. Aureus mediante ensayos antibacterianos ISO22196 (JIS Z 2801:2010), ensayos de adhesión bacteriana y ensayos de transferencia de bacterias de una superficie a otra (touch transfer).
En los siguientes apartados se proporcionan más detalles del tipo de tecnologías y se muestran algunos ejemplos de desarrollos de Tekniker en relación a las capacidades requeridas.
Tecnologías de superficies para soluciones antibacterianas, higiénicas y biocidas a medida
Desde la solución de Superficies Multifuncionales, Tekniker cuenta con una amplia experiencia en distintas tecnologías de funcionalización superficial que permiten al centro dotar a distintos materiales de propiedades antibacterianas, biocidas y de fácil limpieza. En ese sentido, Tekniker dispone de una variedad de tecnologías de recubrimientos, de texturizado superficial y de aditivación de materiales que le permite aplicar la estrategia más adecuada para cada tipo de producto objetivo, en función de sus requisitos, de las condiciones de trabajo y del material en el que se quieren generar las funcionalidades deseadas.
En la figura 1 se resumen las tecnologías disponibles en Tekniker para alcanzar funcionalidades antibacterianas, higiénicas y biocidas.
Para poder ver el contenido completo tienes que estar suscrito. El contenido completo para suscriptores incluye informes y artículos en profundidad